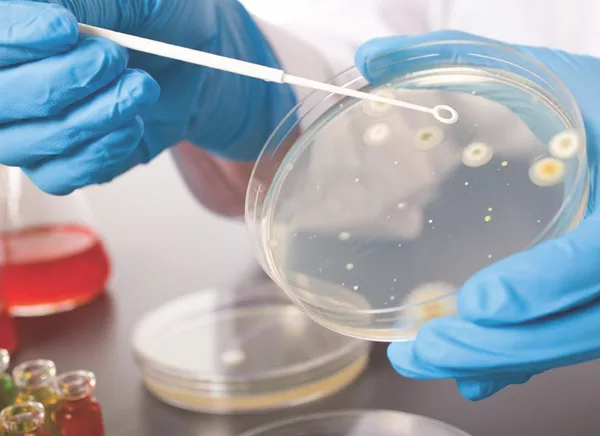

Scientific Literature Alert: Alternative Approaches to the Management of Listeria monocytogenes
Outbreaks due to food contaminated with Listeria monocytogenes continue to occur globally. Noting that many countries around the world have established microbiological criteria for L. monocytogenes of 100 CFU/g in low-risk foods that do not support the growth of the organism, a recent review article published online October 13 in Food Control presents an alternative to the current “zero-tolerance” approach used in the U.S. for all ready-to-eat (RTE) foods, regardless of risk profile. A blanket zero-tolerance policy for all RTE foods provides a very strong disincentive for zone 1 testing, as well as a significant disincentive for finished product testing. More specifically, the challenge with a zero-tolerance approach for all foods is that all positive test results will lead to a recall, therefore potentially limiting the willingness to frequently sample. Moreover, analysis of various alternate sampling approaches demonstrates that using a three-class sampling plan can even be more stringent than the current two-class presence-absence zero-tolerance approach. In addition to more stringent testing, the benefits of not doing a recall on low-risk foods that do not support the growth of L. monocytogenes and that contain only low levels of the pathogen include i) not wasting limited industry and regulator resources; ii) not losing consumer confidence, iii) maintaining a secure and sufficient food supply, iv) decreased food waste, v) avoiding negative effects on the environment, and vi) avoiding unnecessary costly food recalls.
The authors of the review argue that some of the actions that could be undertaken as part of a country’s policy and/or regulatory approach to enhance the control of L. monocytogenes include: i) using alternate sampling approaches to the current two-class sampling plans for low-risk foods that do not support the growth of the organism; ii) using big data to better inform microbial risk assessments; iii) performing a risk-benefit assessment; and iv) developing novel consumer food handling/risk communication strategies.
They conclude by stating that by using all of the described best practices, along with a risk-based policy that treats foods not supporting growth from foods supporting growth differently, that is, not using a zero-tolerance approach for RTE foods not supporting growth of the organism, currently offers the best overall evidence-based scientific approach to the control of L. monocytogenes in RTE foods. The authors recommend that, in general, frozen foods labeled with cooking instructions should be considered as non-RTE foods and must be cooked prior to consumption, and food safety education and guidance to at-risk consumers regarding cooking instructions should be a priority. What is needed is an evidence-based, globally harmonized public health approach to the definitions of RTE and non-RTE foods along with guidance on how these definitions should be applied in any regulatory policy on L. monocytogenes.
Looking for quick answers on food safety topics?
Try Ask FSM, our new smart AI search tool.
Ask FSM →






.webp?t=1721343192)

